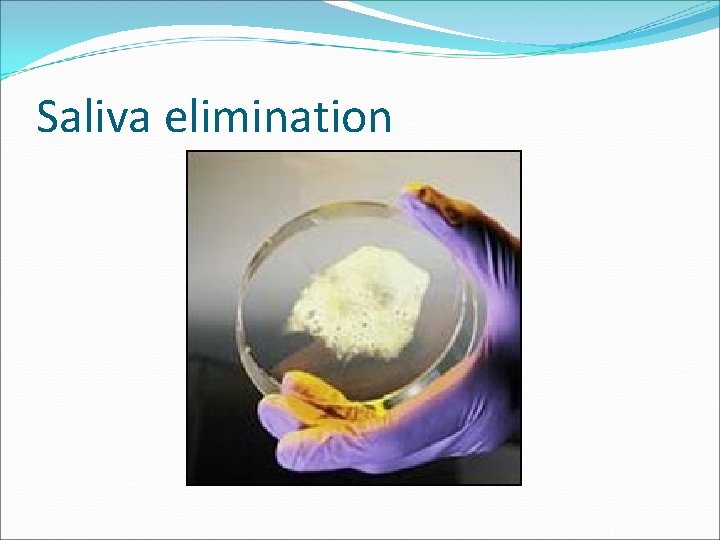
Saliva elimination
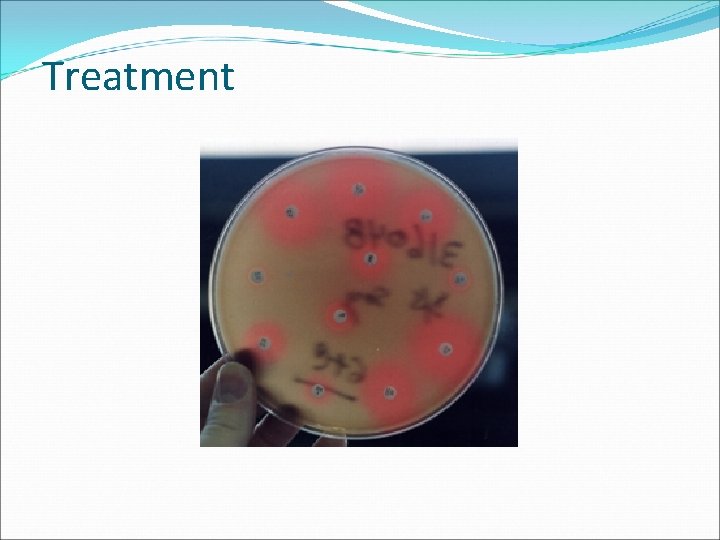
Treatment

Clinical Microbiology Laboratory the place and the contribution

Clinical Microbiology Laboratory: the place and the contribution to clinical field

Analytical curriculum 1. The logic of the Clinical Microbiology. Blood culture in the diagnosis of infections. 2. CSF examination in CNS infectious diagnosis. 3. Laboratory diagnosis of the respiratory tract infectious. 4. Laboratory diagnosis of urinary tract infectious. 5. Laboratory diagnosis of genital tract infectious. 6. Laboratory diagnosis of diarrheic syndrome. Burned wounds infcetions.

Clinical Microbiology: Offers important laboratories data for the etiological diagnosis of the infectious diseases; Aims antimicrobial therapy when it is possible and necessary; Oversee antimicrobial therapy efficiency Is a “work instrument” of the clinician.

The patient ask: I will be O. K. ? / I will die? / I will have side effects ? My family members are safe because of this disease? How much it will cost me?

The hospital managers are asking us: how much it cost ? Direct: diagnosis, therapy, prophylaxis; Indirect: lose of work days.

Physician: judgement Clinical ipothesis Start: the patient with clinical - epidemiologic circumstances Physician: judgement Clinical decision Analysis paper Request of analysis Antibiogram Complete identification Adequate Sample prelevation: Labeling, Conservation transport to laboratories Subcultivation Pre – result, if it is possible Recording Direct exam: Macroscopic/ naked eye; Microscopic; Other methods Identification of clinical semnificative samples Cultivation for isolation: adequate culture media, atmosphere, temperature

Microbiology make observations and measure exposure to the variations and the errors Biological Pre-analytical Analytical Post-analytical

Errors in clinical microbiology Biological errors: vaginal microbial flora at different ages; colonization of old age person’s oropharynx with gram negative bacilli; microbial colonization of the patients with lung diseasses; Preanalytic errors: Physiological: Urine quantity / day; Antimicrobial therapy; Sampling of pathologic products (choosing the right product, moment of sampling, type of sampling), labeling, preservation, transport to the lab, anlysis paper request;

Errors in clinical microbiology Analytical variations: diagnostic kit used (culture media, reagents, instruments, automatic equipments); knowledge and experience of each person from laboratory; Post-analytical variations: between the result obtaining in the lab until it will be received from the clinician; errors regarding miss-copying the results of analysis.

Microbiology make observations and measure exposure to variations and errors Biological errors: pregnancy, children, elderly, associated diseases (diabetus, etc. ) Pre-analytical errors: samples’ s sampling (time, quantity, sterile procedures, etc) Analytical: sensitivity, specificity, reproductibility, etc Post-analytical: results communication (electronic, writing, data transfer, etc)

What and how much must the student and the clinician should know about this?

There is difference between the methods of diagnosis diseases due by pathogenic microorganisms ( classic / emergent); Conditioned pathogenic microorganisms / opportunistics - anti infectious defense deficiency; Poly etiological syndromes; In conditions of the rise of microorganism’s resistance to antibiotics.

Pathogenic microorganisms Qualitative results: - acid fast bacilli = Mycobacterium tuberculosis – lung tuberculosis (the absence from normal flora from respiratory tract); - difficult to analyze for urine: acid fast bacilli can be M. smegmatis (saprophytic bacteria – no pathogen); the need for final identification - Salmonella Typhi – enteric fever - Interpretation for “healthy carriers” ?

Opportunistic bacteria Simple presence = normal High amount (significant amount)+ inflammatory cells = disease e. g. presence of Streptococcus pneumoniae in sputum (106 CFU) e. g. presence of Escherichia coli in urine (105 CFU – colony forming units)

Acute lobar pneumonia – sample prelevation


Examination (macroscopically – naked eye)


Sputum sample (tuberculosis)
Saliva elimination

S. pneumoniae – sputum smear 1000 X

S. pneumoniae – sputum smear 1000 X (QS > +1)

100 x – CES – NO EXAMINATION whith 1000 X

Acid fast bacilli

Sputum cultivation


Streptococcus pneumoniae – sensitivity to optochin α haemolytic colonies

Identification (Ag – Ab reaction)

Treatment

Charles Nicolle’ s foreseeing – 1932 “ there is will be new diseases, one of them will slow disappear, and other will manifest in forms which today we don’t know…”

Clinical microbiology’s exigency: Performance methods: efficiency versus effectivenes, accuracy; Performance of the methods: Informational tide controlled between clinics and laboratories; Norms and standardize.

Test efficiency Sensitivity Specificity Predictive positive Predictive negative TEST’S EFFICIENCY

Pathologic circumstance Test’s results Present Absent Totals Positive a c a+c Negative b d b+d Totals a+b c+d N

Specificity is the percentage of person who do not have a disease who yield a negative test result d / c +d; Sensitivity is the percentage of a individuals with a specific disease who yield a positive result a / a + b; Predictive value for a positive test is a proportion of those who have a disease among those who gave positive results: a / a + c; Predictive negative value of the test is a proportion of those who do not have disease among those who gave negative test results : d / b +d. Efficiency measure the proportion of the correct diagnosis classification: a +d / N.

Precision The similitude between the results of the same repeated test on similar samples from the same patients




Standardize norms: Norms of sampling; Transport; Preservation for quality.

The quality manual of laboratories: Methodologies and technical – all the time at disposition. “Now phone without wire” The guarantee for the reactive’ s quality: certificate of quality; Precision of equipments; Quality control.

Laboratory accreditation Internal versus external quality control Procedures (for all operations: sampling, smear examination, cultivation and culture media, sterilization, etc) Accreditation for each tests (ELISA, isolation and identification of Streptoccous pneumoniae in sputum, etc)
- Slides: 42